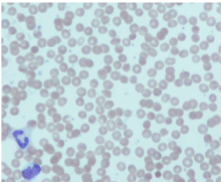

The growth promoting effects of Growth Hormone (GH) are mostly mediated by which of the following?
A. Growth hormone releasing hormone.
B. IGF1 (Insulin-like Growth Factor One).
C. IGF2 (Insulin-like Growth Factor Two).
D. IGFBP3 (Insulin-like Growth Factor Binding Protein Three).
E. Insulin.
B. IGF1 (Insulin-like Growth Factor One).
Malrotation with midgut volvulus is a potentially life threatening condition in otherwise healthy infants. Which of the following best describes the normal rotation of the bowel that occurs during embryogenesis?
A. Clockwise 180 degrees.
B. Clockwise 270 degrees.
C. Counterclockwise 90 degrees.
D. Counterclockwise 180 degrees.
E. Counterclockwise 270 degrees.
E. Counterclockwise 270 degrees.
A three-year-old child undergoes cardiac catheterization. The saturations obtained in room air during the procedure are as follows:
Superior vena cava 75%
Right atrium 75%
Inferior vena cava 75%
Right ventricle 75%
Main pulmonary artery 87%
Left ventricle 99%
Aorta 99%
The most likely cardiac abnormality that this child has is:
A. atrial septal defect.
B. atrial septal defect with partial anomalous pulmonary venous drainage.
C. patent ductus arteriosus.
D. ventricular septal defect.
E. ventricular septal defect with Eisenmenger’s complex.
C. patent ductus arteriosus.
In an X-linked disorder which has no effect on reproductive fitness or life expectancy, the expected ratio of affected (hemizygous) males to carrier (heterozygous) females is closest to:
A. 1:3.
B. 1:2.
C. 1:1.
D. 2:1.
E. 3:1.
B. 1:2.
Which biochemical abnormality is most consistently found in infants subjected to severe environmental deprivation?
A. Decreased cortisol.
B. Hyperglycaemia.
C. Hypoglycaemia.
D. Hypothyroidism.
E. Increased cortisol.
E. Increased cortisol.
At what age does physical aggression peak across populations?
A.1-2 years.
B.2-3 years.
C.5-6 years.
D. 8-10 years.
E.14-18 years.
B.2-3 years
A nine-year-old girl is referred from the surgical clinic, where evaluation of recurrent abdominal pain included the following blood film. Her mother required cholecystectomy for gallstones at 19 years of age, and her maternal grandfather is thought to have had a splenectomy as a young adult.
Which of the following tests is likely to be abnormal?
A. Acid serum lysis (Ham’s) test.
B. Bone marrow flow cytometry.
C. Direct antiglobulin (Coombs’) test.
D. Glucose-6-phosphate dehydrogenase level.
E. Osmotic fragility test.
E. Osmotic fragility test.
- Osmotic fragility test: Osmotic fragility measures red blood cell (RBC) resistance to hemolysis when exposed to a series of increasingly dilute saline solutions. The sooner hemolysis occurs, the greater the osmotic fragility of the cells. – indicates hereditary spherocytosis or thalassaemia
- Ham’s test: HAM test is used to evaluate patients with suspected PNH (Paroxysmal Noctural Hemoglobinuria) or suspected congential dyserythropoietic anemia, especially with hemosiderinuria, Pancytopenia, decreased RBC acetyl cholinesterase, decreased leukocyte alkaline phosphatase, negative direct Coomb’s test, and/or apparent marrow failure.
- BM Flow cytometry: differentiate cells
- DAT: for antibody mediated haemolysis
S&S of hereditary spherocytosis:
Anaemia, splenomegaly (breakdown of spherocytes in spleen), gallstones (inc bile from RBC breakdown)
Film: spherocytes (small diameter, hyperchromic, less central pallor), >15-20% of cells when haemolytic anaemia present
A seven-year-old girl with Morquios syndrome is referred for respiratory assessment prior to a surgical procedure. Her lung function demonstrated the following:
The most likely explanation for this pattern is:
A. decreased chest wall compliance.
B. decreased small airway conductance.
C. increased upper airway resistance.
D. increased chest wall compliance.
E. narrowing of the trachea.

A. decreased chest wall compliance.
Dec TLC → unable to expand wall, inc RV → obstructive, dec FRC → dec with TLC?
Likely to have dec chest wall compliance from skeletal abns, which is consistent with results
Morquios syndrome
mucopolysaccharidosis (MPS-IV), short-trunk dwarfism, fine corneal deposits, skeletal dysplasia and preservation of intelligence
PFTs
- Restrictive disease – decreases total lung capacity (incls residual volume), decreases vital capacity
- Obstructive disease – produces gas trapping → increases residual volume and FRC esp when considered with respect to TLC
A study is comparing the bioavailability of a new oral preparation of a drug (100 mg tablet) with the marketed intravenous preparation (50 mg in 2 mLs). In this crossover study, healthy volunteers were given in random order one 100 mg tablet or 50 mg intravenously (IV). The drug has linear kinetics within the range of concentrations studied. The mean results are as follows:
Which of the following is the best estimate of the oral bioavailability of the tablet?
A. 12.5%.
B. 40%.
C. 50%.
D. 90%.
E. 96%.

D. 90%
Absolute bioavailability compares the bioavailability of the active drug in systemic circulation following non-intravenous administration (i.e., after oral, rectal, transdermal, subcutaneous, or sublingual administration), with the bioavailability of the same drug following intravenous administration.
The absolute bioavailability is the dose-corrected area under curve (AUC) non-intravenous divided by AUC intravenous.
Causes of low bioavailability: Orally administered drugs must pass through the intestinal wall and then through the portal circulation to the liver; both are common sites of 1st-pass metabolism (metabolism of a drug before it reaches systemic circulation). Thus, many drugs may be metabolized before adequate plasma concentrations are reached. Low bioavailability is most common with oral dosage forms of poorly water-soluble, slowly absorbed drugs.
Insufficient time for absorption in the GI tract is a common cause of low bioavailability. If the drug does not dissolve readily or cannot penetrate the epithelial membrane (eg, if it is highly ionized and polar), time at the absorption site may be insufficient. In such cases, bioavailability tends to be highly variable as well as low.
Age, sex, physical activity, genetic phenotype, stress, disorders (eg, achlorhydria, malabsorption syndromes), or previous GI surgery (eg, bariatric surgery) can also affect drug bioavailability.
The addition of starch to oral rehydration solution increases water absorption by which mechanism?
A. Aquaporin transport.
B. Colonic fermentation.
C. Enterohepatic reabsorption.
D. Sodium-glucose co-transport.
E. Sodium-Potasium A TPase.
B. Colonic fermentation
In the fetus with a structurally normal heart. The percentage of pulmonary arterial blood flow that is directed through the ductus arteriosus is:
A. 10.
B. 30.
C. 50.
D. 70.
E. 90.
E. 90.
During acute hypovolaemia, which of the following mediators produces dilation of the renal afferent arteriole?
A. Aldosterone.
B. Angiotensin II.
C. Anti diuretic hormone.
D . Prostaglandin I2.
E. Thromboxane.
D . Prostaglandin I2.
When renal blood flow is reduced (indicating hypotension) or there is a decrease in sodium and chloride ion concentration, the macula densa of the distal tubule releases prostaglandins, which cause the juxtaglomerular cells lining the afferent arterioles to release renin, activating the renin-angiotensin-aldosterone system, to increase blood pressure and increase retention of sodium ions via aldosterone.
The macula densa cell can also increase the local blood pressure of the afferent arterioles by increasing the synthesis of nitrous oxide or decreasing the synthesis of adenosine or ATP.
If the afferent arterioles are constricted then the blood pressure in the capillaries of the kidneys will drop.
A two-year-old boy presents with an incidentally noted abdominal mass. He is found to have sparse pubic hair. Investigation confirms he has a hepatoblastoma.
Virilization is most likely in children with ectopic production of:
A. alpha fetoprotein.
B. androstenedione.
C. human chorionic gonadotrophin
D. luteinizing hormone
E. testosterone.
C. human chorionic gonadotrophin
A woman presents for genetic counselling early in her first pregnancy. Her husband has a disorder caused by a mitochondrial DNA point mutation; several other members of his family are also affected.
The risk that this baby will be affected by the same condition is closest to:
A. 0%.
B. 5%.
C. 25%.
D. 50%.
E. 100%.
A. 0%.
Mitochondria contain own chromosomes, which are maternally derived. Diseases with mitochondrial mutations have inheritance through maternal line eg mitochondrial myopathies (MELAS and MERRF)
A 12-year-old girl presents to the Emergency Department following a motor vehicle accident complaining of neck pain. She was a front seat passenger wearing a seat belt in a stationary car which was hit from behind by a vehicle travelling at approximately 30 kilometers per hour. On examination she has no bony tenderness and full neck movements with no neurological deficit.
Which of the following best describes the lateral cervical spine radiograph shown above?
A. Fracture C2 pedicles.
B. Fracture odontoid peg.
C. Pseudosubluxation of C2 on C3.
D. Spondylolisthesis of C2 on C3.
E. Anterior wedge fracture C3.

C. Pseudosubluxation of C2 on C3.
Pediatric pseudosubluxation refers to normal mobility of C-2 on C-3 in flexion which may be so pronounced as to be mistake for pathologic motion; (is normal in children < 8 years old);
Pseudosubluxation may be seen in 40% of children at C2-C3 level and in 14% of children at the C3-C4 level
etiology:
- pediatric C-spine (up to 8 yrs of age) has greatly increased physiologic mobility as compared to the adult;
- occurs because of increased ligamentous laxity, more horizontal nature of facet joint (30 deg vs. 60-70 deg in adult);
- in children, fulcrum of motion that is relatively greatest at C2-C3 level (compared w/ C5-C6 in the adult);
- 70% of C-spine frx in infants and children occur from C1 to C3;
- hence increase frequency of atlantoaxial rotatory subluxation as compared to the adult;
- in normal circumstances, this anterior displacement only occurs in flexion, and should not occur in extension;
Children who are born with extremely low birth weight are surviving at higher rates than ever before. What is the prevalence of severe neurological disability in surviving children who are born with extremely low birth weight?
A. Less than 10%.
B. 10 to 20%.
C. 30 to 40%.
D. 50 to 60%.
E. Over 80%.
B. 10 to 20%
The anterior pituitary gland releases all of the following hormones except:
A. adrenocorticotropin.
B. growth Hormone.
C. leuteinising hormone.
D. thyroid stimulating hormone.
E. vasopressin.
E. vasopressin.
The key event which directly initiates myocardial fibre contraction is:
A. active uptake of calcium into sarcoplasmic reticulum.
B. rapid entry of sodium through fast ion specific channels.
C. release of stored calcium from sarcoplasmic reticulum.
D. slow inward calcium current.
E. slow inward sodium current.
C. release of stored calcium from sarcoplasmic reticulum.
Lymph nodes are the major site for interaction between antigen presenting cells and:
A. B cells.
B. macrophages .
C. neutrophils.
D. NK cells.
E. T cells.
E. T cells.
Adolescence represents a stage of development where a number of cognitive and psychosocial tasks must be mastered.
Which one of the following is not a task of adolescence?
A. Concrete operational thinking.
B. Establishing stronger peer group relationships.
C. Forming sexual relationships.
D. Identity formation.
E. Separation from the family group.
A. Concrete operational thinking.
Which measure on spirometry is the most sensitive in children with small airways disease?
A. Forced Vital Capacity (FVC).
B. Forced Expiratory Volume in 1 second (FEV1).
C. Forced Expiratory Flow 25%-75% (FEF 25%-75%).
D. Peak flow.
E. FEV1/FVC ratio.
C. Forced Expiratory Flow 25%-75% (FEF 25%-75%).
FEV1 correlates well with severity of obstructive disease
Maximal midexpiratory flow rate (average flow during middle 50% for forced vital capacity) is more reliable indicator of mild airway obstruction with sensitivity to changes in residual volume and vital capacity
- flow rate at 25% VC is useful index of small airway function
Peak flow reduced in advanced obstructive disease but may not be altered when obstruction is moderate or mild and need cooperation
FEV1/FVC ration ie the proportion of the vital capacity exhaled in the first second – distinguishes between reduced FEV1 due to restricted lung volume and that due to obstruction. Obstruction is defined as an FEV1/FVC ratio of <70%
An otherwise well ten-year-old boy has chronic kidney disease secondary to posterior urethral valves. His mother has noted that he is often very thirsty and drinks up to 2500mls of fluids per day.
A. 5%.
B. 10%.
C. 20%.
D. 30%.
E. 40%.

A. 5%.
100x (70x0.2)/(140x2) = 5
The fractional excretion of sodium (FENa) is the percentage of the sodium filtered by the kidney which is excreted in the urine. It is measured in terms of plasma and urine sodium, rather than by the interpretation of urinary sodium concentration alone, as urinary sodium concentrations can vary with water reabsorption.
In clinical use, the fractional excretion of sodium can be calculated as part of the evaluation of acute renal failure in order to determine if hypovolemia or decreased effective circulating plasma volume is a contributor to the renal failure. “Measurement of the urine sodium concentration provides information on the integrity of tubular reabsorptive function. Low urine sodium concentration thus indicates not only intact reabsorptive function but also the presence of a stimulus to conserve sodium “

A 15-year-old with a history of complex partial seizures is currently on carbamazepine. He develops acute sinusitis and is prescribed an antibiotic by his general practitioner. He presents to the emergency room with depressed conscious state and status epilepticus. He is found to have markedly elevated carbamazepine levels.
Which of the following antibiotics is he likely to have been prescribed?
A. Amoxicillin-clavulinic acid.
B. Cefaclor.
C. Ciprofloxacin.
D. Doxycycline.
E. Erythromycin
E. Erythromycin.
Carbamazepine is a CYP 3A4 substrate as well as an inducer of multiple cytochrome P450 isoenzymes and may be subject to a number of drug-drug interactions. Toxic levels of carbamazepine may result from CYP 3A4 inhibition due to erythromycin, fluoxetine, and cimetidine, among other drugs.
CYP 3A4 inducers, such as phenytoin and phenobarbital, may decrease carbamazepine levels. Plasma levels of many medications, including haloperidol and clozapine, are reduced in the setting of carbamazepine use.
A previously well 14-year-old boy presents to the emergency department with a history of increasing wheeze and shortness of breath over several days. On examination, he has facial fullness and erythema, and his neck veins are easily visible. His chest X-ray is shown below.
A radiologically guided biopsy yields tissue consistent with lymphoblastic lymphoma. Immunocytochemistry is likely to show the cells originate from which lymphocyte group?
A. Mature B cells.
B. Natural killer (NK) cells.
C. Precursor B cells.
D. Reed-Sternberg cells.
E. T cells.

E. T cells.
T-cell ALL: obstruction from anterior mediastinal mass (thymus or nodes) – mostly seen in adolescent boys with T-cell ALL (T-cell ALL also has higher leukocyte count), 50-75% Reed-Sternberg cells (Hodgkins)











